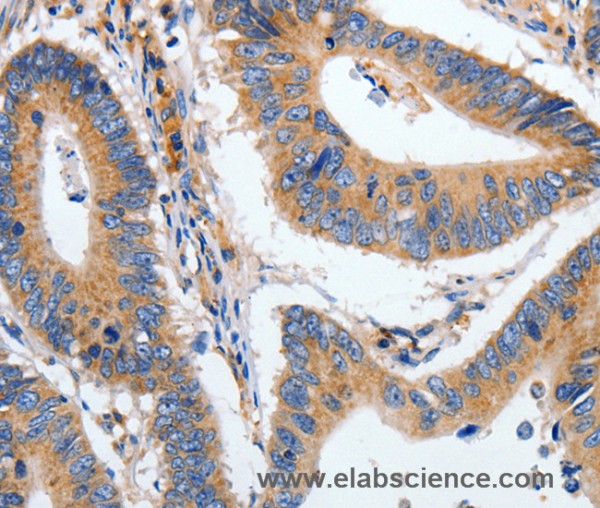
Anti-HSPA1A

Cookie preferences
This website uses cookies, which are necessary for the technical operation of the website and are always set. Other cookies, which increase the comfort when using this website, are used for direct advertising or to facilitate interaction with other websites and social networks, are only set with your consent.
Configuration
Technically required
These cookies are necessary for the basic functions of the shop.
"Allow all cookies" cookie
"Decline all cookies" cookie
CSRF token
Cookie preferences
Currency change
Customer-specific caching
FACT-Finder tracking
Individual prices
Selected shop
Session
Comfort functions
These cookies are used to make the shopping experience even more appealing, for example for the recognition of the visitor.
Note
Show the facebook fanpage in the right blod sidebar
Statistics & Tracking
Affiliate program
Conversion and usertracking via Google Tag Manager
Track device being used
If you have any questions, please use our Contact Form.
You can also order by e-mail: info@biomol.com
Larger quantity required? Request bulk
You can also order by e-mail: info@biomol.com
Larger quantity required? Request bulk
This intronless gene encodes a 70kDa heat shock protein which is a member of the heat shock... more
Product information "Anti-HSPA1A"
This intronless gene encodes a 70kDa heat shock protein which is a member of the heat shock protein 70 family. In conjuction with other heat shock proteins, this protein stabilizes existing proteins against aggregation and mediates the folding of newly translated proteins in the cytosol and in organelles. It is also involved in the ubiquitin-proteasome pathway through interaction with the AU-rich element RNA-binding protein 1. The gene is located in the major histocompatibility complex class III region, in a cluster with two closely related genes which encode similar proteins. Protein function: Molecular chaperone implicated in a wide variety of cellular processes, including protection of the proteome from stress, folding and transport of newly synthesized polypeptides, activation of proteolysis of misfolded proteins and the formation and dissociation of protein complexes. Plays a pivotal role in the protein quality control system, ensuring the correct folding of proteins, the re-folding of misfolded proteins and controlling the targeting of proteins for subsequent degradation. This is achieved through cycles of ATP binding, ATP hydrolysis and ADP release, mediated by co-chaperones. The co-chaperones have been shown to not only regulate different steps of the ATPase cycle, but they also have an individual specificity such that one co-chaperone may promote folding of a substrate while another may promote degradation. The affinity for polypeptides is regulated by its nucleotide bound state. In the ATP-bound form, it has a low affinity for substrate proteins. However, upon hydrolysis of the ATP to ADP, it undergoes a conformational change that increases its affinity for substrate proteins. It goes through repeated cycles of ATP hydrolysis and nucleotide exchange, which permits cycles of substrate binding and release. The co-chaperones are of three types: J-domain co-chaperones such as HSP40s (stimulate ATPase hydrolysis by HSP70), the nucleotide exchange factors (NEF) such as BAG1/2/3 (facilitate conversion of HSP70 from the ADP- bound to the ATP-bound state thereby promoting substrate release), and the TPR domain chaperones such as HOPX and STUB1 (PubMed:24012426, PubMed:26865365, PubMed:24318877). Maintains protein homeostasis during cellular stress through two opposing mechanisms: protein refolding and degradation. Its acetylation/deacetylation state determines whether it functions in protein refolding or protein degradation by controlling the competitive binding of co-chaperones HOPX and STUB1. During the early stress response, the acetylated form binds to HOPX which assists in chaperone-mediated protein refolding, thereafter, it is deacetylated and binds to ubiquitin ligase STUB1 that promotes ubiquitin-mediated protein degradation (PubMed:27708256). Regulates centrosome integrity during mitosis, and is required for the maintenance of a functional mitotic centrosome that supports the assembly of a bipolar mitotic spindle (PubMed:27137183). Enhances STUB1-mediated SMAD3 ubiquitination and degradation and facilitates STUB1-mediated inhibition of TGF-beta signaling (PubMed:24613385). Essential for STUB1-mediated ubiquitination and degradation of FOXP3 in regulatory T-cells (Treg) during inflammation (PubMed:23973223). Negatively regulates heat shock- induced HSF1 transcriptional activity during the attenuation and recovery phase period of the heat shock response (PubMed:9499401). [The UniProt Consortium]
| Keywords: | Anti-HSPA1A, Anti-HSP70.1, Anti-HSP70-1, Anti-Heat shock 70 kDa protein 1, Anti-Heat shock 70 kDa protein 1A, HSPA1A Polyclonal Antibody |
| Supplier: | Elabscience |
| Supplier-Nr: | E-AB-14137 |
Properties
| Application: | IHC, ELISA |
| Antibody Type: | Polyclonal |
| Conjugate: | No |
| Host: | Rabbit |
| Species reactivity: | human, mouse, rat |
| Immunogen: | Recombinant protein of human HSPA1A |
| Format: | Purified |
Database Information
| KEGG ID : | K03283 | Matching products |
| UniProt ID : | P0DMV8 | Matching products |
| Gene ID : | GeneID 3303 | Matching products |
Handling & Safety
| Storage: | -20°C |
| Shipping: | 4°C (International: -20°C) |
Caution
Our products are for laboratory research use only: Not for administration to humans!
Our products are for laboratory research use only: Not for administration to humans!
Information about the product reference will follow.
more
You will get a certificate here
Viewed

